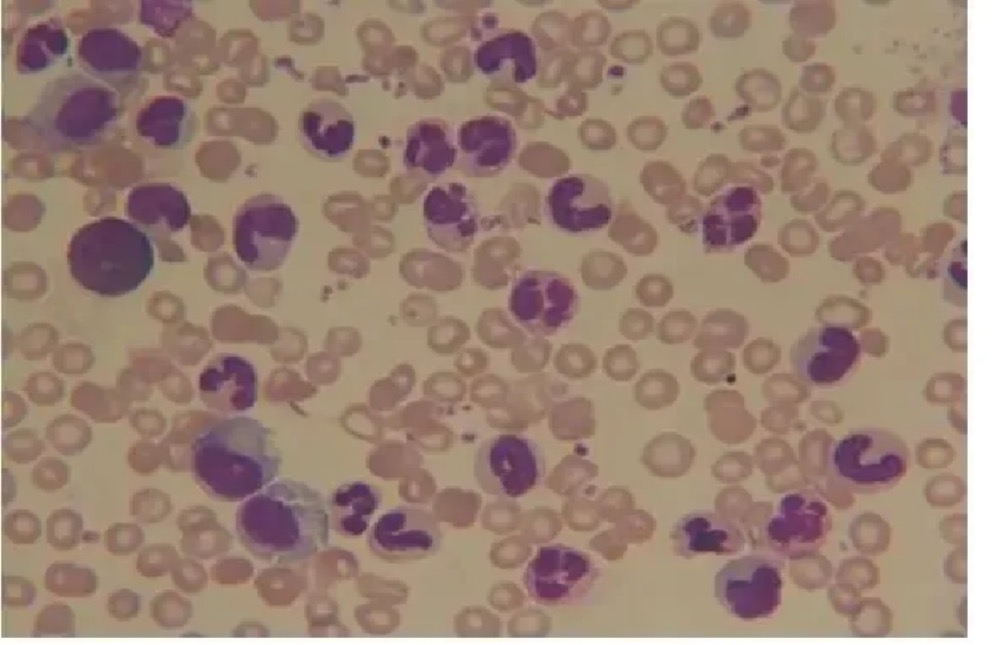
25578_p4ou_4668.jpg
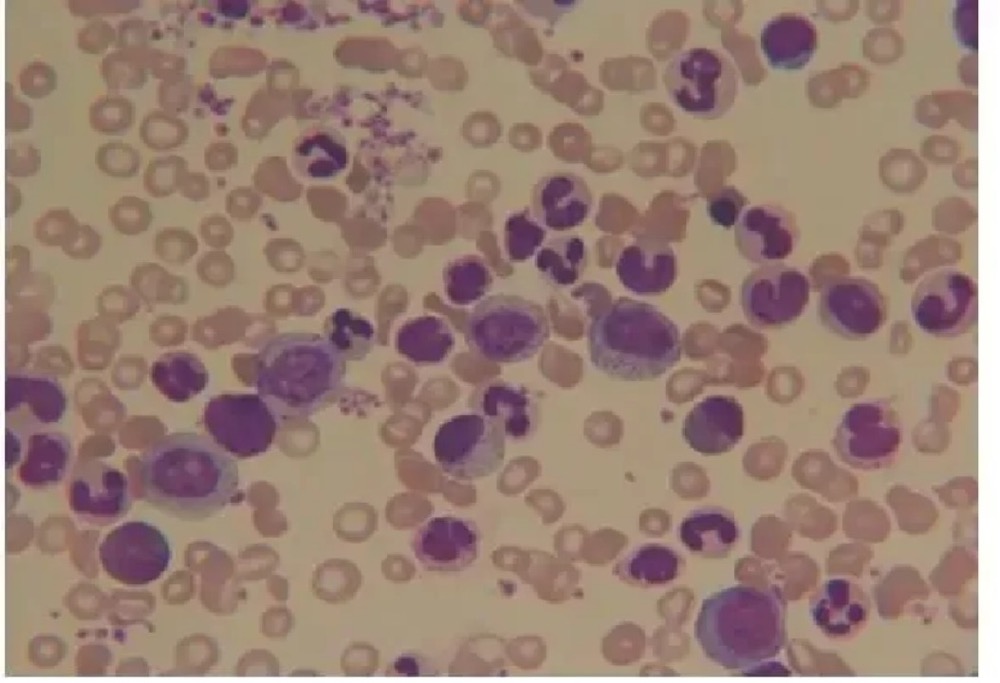
25578_f4hj_8535.jpg

提到白血病,大部分人谈癌色变,认为是不治之症!但白血病中有一种特殊的白血病,它同其他白血病不一样,不需要经历痛苦的化疗过程,只需要口服靶向药物便可以有效控制病情,就像糖尿病、高血压患者一样规律服用即可,从外表上看完全不像“病人”,可以正常工作、生活、结婚,从事自己喜欢的运动,这样的状态可维持10多年甚至可以停药,因此也被称为“幸运的白血病”——慢性髓性白血病(CML)。
慢性髓性白血病( CML)简介?
慢性髓性白血病(chronic myelogenous leukemia, CML)是一种以髓系增生为主的造血干细胞恶性疾病。CML的病因是患者体内第9号和第22染色体发生断裂易位形成费城染色体(Ph染色体)导致BCR-ABL融合基因产生,调控机体产生过多异常的粒细胞。CML 全球的年发病率为(1~2)/10 万,占成人白血病总数的 15%~20%,各个年龄组中均可发生;随着年龄增长发病率逐渐增加,中位诊断年龄在亚洲国家偏年轻(40~50 岁),欧美国家年长(55~65 岁),男女比例约 1.4∶1,自然病程为 3~5 年。CML曾经是“不治之症”。随着2001年全球第一个酪氨酸激酶抑制剂(tyrosine kinase inhibitor,TKI)伊马替尼的出现,标志着慢粒的治疗从此进入靶向治疗时代,慢粒已经从“不治之症”转变为可治可控的“慢病”。
随着新药的不断开发,CML患者的生存得到了显著提升。2017年欧洲血液学年会(EHA)公布的一项CML长期随访结果显示,CML患者经伊马替尼治疗后总生存获益显著,几乎达到了正常寿命。正因为良好的预后,慢性粒细胞白血病被称为“幸运的”白血病。
慢性髓性白血病( CML)临床表现
大多数患者在慢性期确诊,通常起病隐袭。近20%-40%的患者无症状,在常规体检时发现白细胞(WBC)数量异常才确诊。
就诊时常见症状包括乏力、体重减轻、盗汗、脾脏肿大和贫血。不典型的表现包括显著血小板增多而白细胞数量多不明显以及初诊时即为急变期而无先前可察觉的慢性期。
实验室检查
(一)血常规
WBC 增多,可伴有血红蛋白下降或血小板增多。外周血白细胞分类可见不成熟粒系细胞,嗜碱性粒细胞和嗜酸性粒细胞增多。
典型的CML血常规检测报告
(二)骨髓形态学。
增生极度活跃,以粒系增生为主,可伴有巨核细胞系增生,相对红系增殖受抑。
典型CML骨髓涂片
(三)细胞遗传学、分子学分析
以显带法进行染色体核型,可见 费城染色体(Ph)。
图片来源于网络
费城染色体(Ph)是由9号染色体长臂(9q34)位置和22号染色体长臂(22q11)位置各自发生断裂并相互交换位置,然后这些染色体碎片在22号染色体上融合在一起,形成的一个新的异常的染色体,这个新的异常的22号染色体被称为费城染色体。
BCR-ABL1融合基因 9号染色体断裂的片段携带一个叫做ABL的基因,22号染色体的片段携带一个叫做BCR的基因。随着染色体片段的交换易位,这些染色体片段上的基因在22号染色体上融合在一起,就形成了一个新的基因,即 BCR-ABL 融合基因。
外周血或骨髓标本经逆转录聚合酶链反应(reverse transcription PCR,RT-PCR)检测,确认存在 BCR-ABL1 融合基因。如果 BCR-ABL1 融合基因为阴性,则需检测 JAK2、CARL和 MPL 突变等髓系增殖性肿瘤相关的基因突变。
疾病分期
CML 的疾病过程一般分为 3 个阶段:慢性期(chronic phase,CP)、加速期(accelerated phase,AP)和急变期(blast phase,BP)。
注:WHO 标准中原始细胞可来源于髓系(包括中性粒细胞、嗜酸性粒细胞、嗜碱性粒细胞、单核细胞、红系、巨核系或上述任意组合)和/或淋巴系,对于少数形态学难以分辨原始细胞来源者,推荐免疫分型予以确认;片状和簇状巨核细胞增生伴有显著的网硬蛋白或胶原蛋白纤维化和/或严重粒细胞发育不良提示加速期。上述现象常伴随加速期其他特征,目前尚未作为独立诊断依据。
治疗
CML的主要治疗方法有靶向治疗、异基因造血干细胞移植(HSCT)和其他治疗(化疗或干扰素)。
图片来源于网络
2000 年后,针对 CML 发病机制中关键靶分子 BCR-ABL 融合蛋白研发上市的首个 TKI 药物——甲磺酸伊马替尼,开启了CML的靶向治疗时代。伊马替尼能相对特异的抑制BCR-ABL激酶活性,在体外实验中,抑制 CML 细胞增殖,并诱导其凋亡。伊马替尼的问世,显著地改善了 CML 患者生存期,80%~90%的患者的生存期接近正常人,并提高了患者的生活质量。
需要注意的是,TKI时代慢粒的预期寿命虽已经接近正常人群,但要达到长期生存甚至实现TFR(无治疗缓解)的治疗目标,还必须坚持规律服药、定期疗效监测。
CML治疗是一个持续的过程,一定要遵医嘱做好下面四件事
按时服药
按医嘱足量服药
定期复查、按时监测
及时处理药物不良反应
得了慢髓性白血病(CML)不用怕,随着早诊早治手段的增多和医药科技的进步, CML已经不是不治之症,而成为了一个慢性疾病,患者可以像正常人一样生活。但若作为一名CML患者,您仍应对自己的疾病给予重视,毕竟CML是恶性肿瘤,一旦进入加速期、急变期仍然可以致死。因此提醒大家,如在体检时发现白细胞计数过高或者多次复查白细胞均异常的情况,无论有无头晕乏力、腹部饱胀、体重减轻等情况,就必须重视起来及时来医院就诊明确白细胞增高的原因。
参考文献:慢性髓性白血病诊疗指南(2022年版)